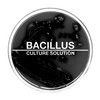

Bacillus
 The Prodromal Onset of Degradation
The Prodromal Onset of Degradationby Bacillus/GX Jupitter-Larsen
 Freedom Sores
Freedom Sores Variants Of Concern
Variants Of Concern Delta
Delta Co-Morbidities of the Long-Haulers
Co-Morbidities of the Long-Haulers Quarantined
Quarantined Culture Solution
Culture Solution Mask It Or Casket
Mask It Or Casket N100
N100by Bacillus/Vomir
 From Voyeur To Victim
From Voyeur To Victim I Hope You Get Better Soon But You Probably Won't
I Hope You Get Better Soon But You Probably Won't The Immunes
The Immunes Death Past Capacity
Death Past Capacity Anti-Vaxxer
Anti-Vaxxer Nightmare Bacteria
Nightmare Bacteria Tertiary Syphilis
Tertiary Syphilisby Macrobacillus
 Out of Control
Out of Control Serial Infector
Serial Infector Anthracis
Anthracis Re-Emergence
Re-Emergence